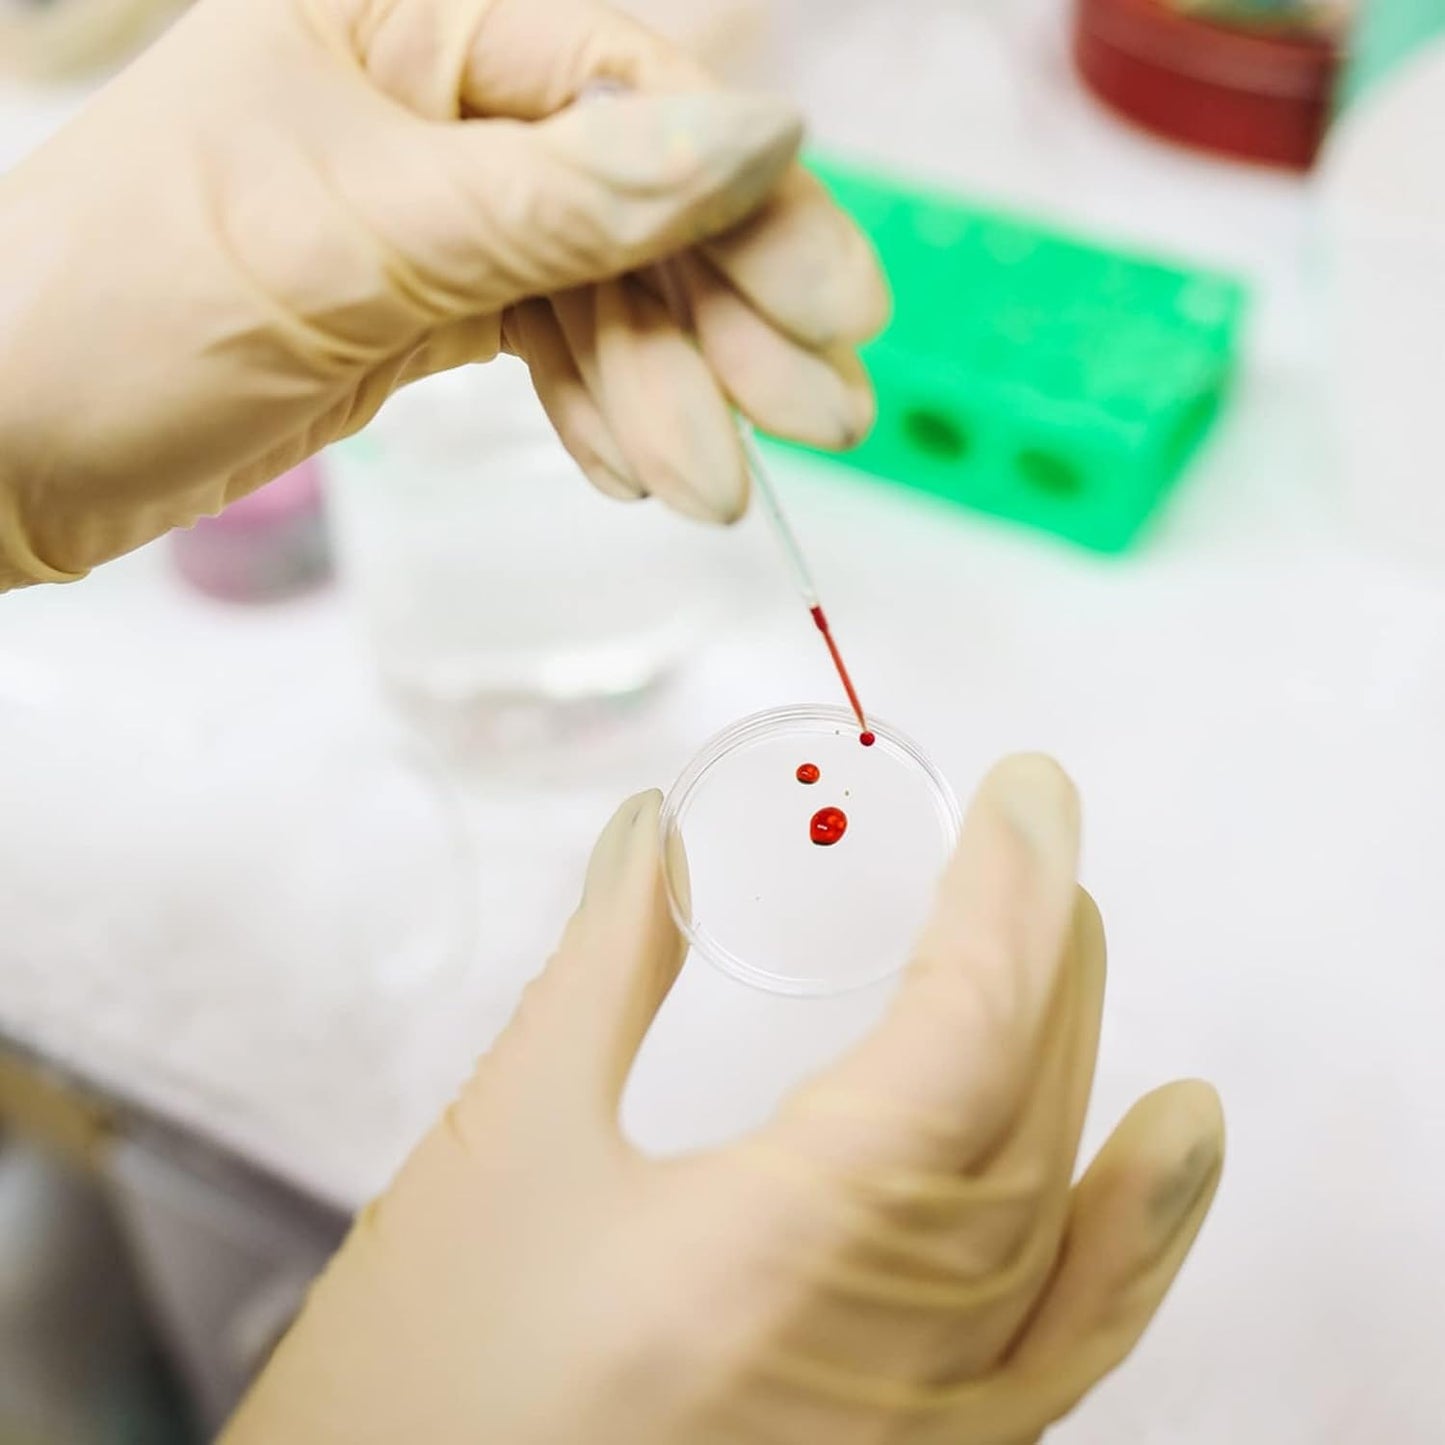
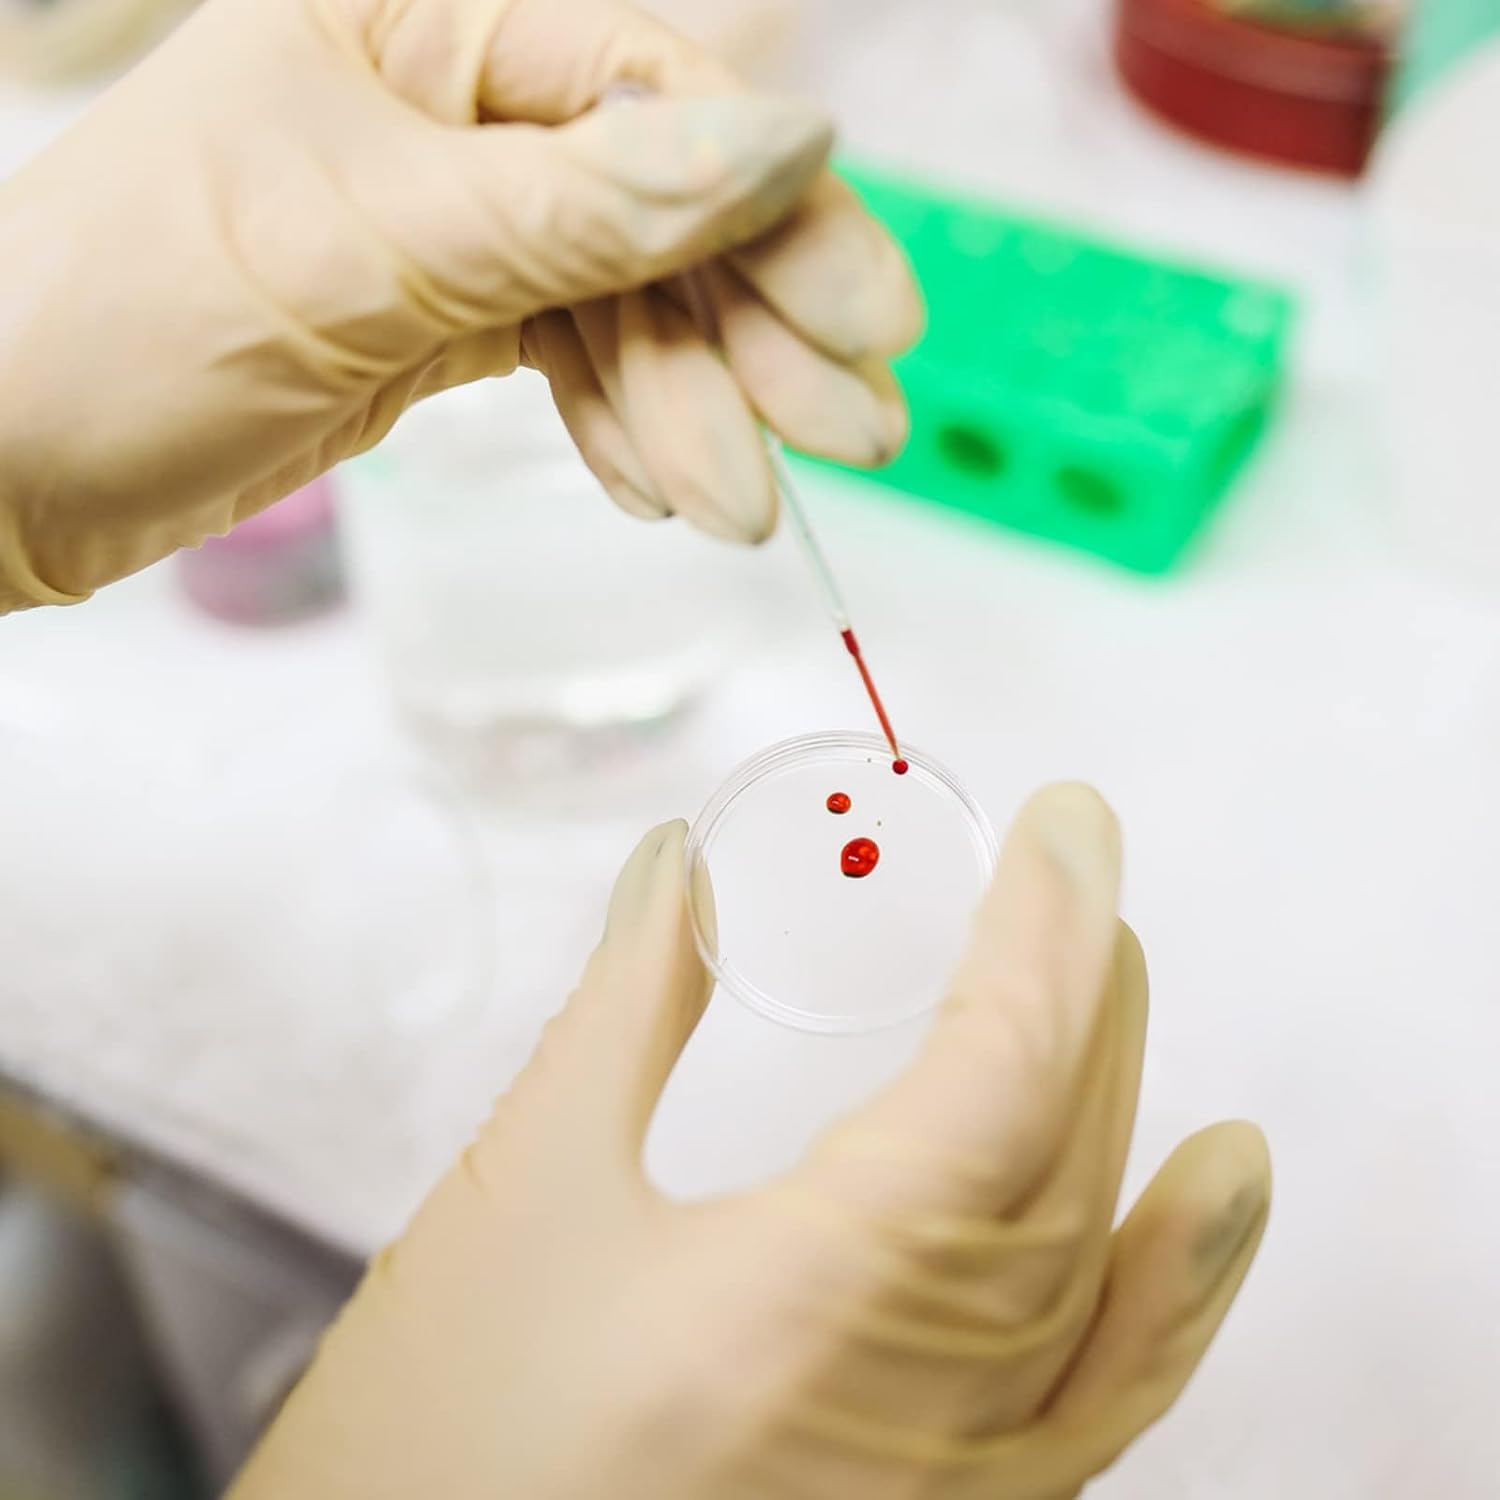

MEUBON
500 Pcs Sterile Plastic Petri Dishes with Lids & 3 Vents – 60mm x 15mm, RNase/DNase Free, Non-Pyrogenic, 200 Packs
In stock
Couldn't load pickup availability
Premium Quality Construction:
Crafted from high-grade plastic, these Petri dishes with lids offer superior clarity, strength, and durability—ideal for professional and educational lab use.
Standard Size for Versatile Use:
Each dish measures 60mm in diameter and 15mm deep, providing sufficient space for culturing, experimentation, and sample observation.
Crystal-Clear Transparency:
Designed for precise analysis, the ultra-clear plastic ensures excellent visibility for observing microbial growth, cell behavior, and other scientific processes.
Enhanced Airflow with Vented Lids:
Each dish features a lid with 3 vents to promote improved air circulation, supporting optimal growth conditions in culture environments.
Available in Multiple Quantities:
Choose from packs of 500 or 2,090 to suit labs of all sizes—from small-scale classroom settings to high-volume research facilities.